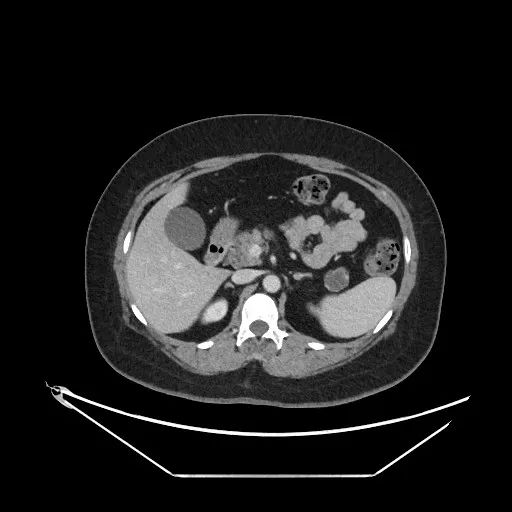

8月12日,广济医院手术室内,来自上海瑞金医院普外科副主任施昱晟教授正为一名胰腺占位性病变的患者实施精准切除手术。“长三角优质医疗重点转化中心”落地淮南后,“家门口的上海医疗”正式进入常态化阶段。


患者刘女士(化名)数月前体检发现胰尾部有一枚肿物,近期就诊上腹部MR增强提示:“胰尾部囊性占位,粘液性囊腺瘤可能”。为进一步治疗,7月27日,患者在家人的陪伴下,赶到广济医院问诊瑞金专家,上海瑞金医院普外科施昱晟教授详细评估后为其制定手术方案。完善术前准备后,施教授专程赴淮,带领东方普外团队顺利完成手术。“从求诊到开刀,专家和先进技术都在淮南解决,免了我们家属奔波之苦,更救了我们家人的命啊!”家属感慨地说。

次日,患者状态良好。“手术的成功不但提高了东方医院集团广济医院肝胆胰等复杂病症的诊治能力和管理水平,也实现了把国内顶级医疗技术惠及更多淮南市民的愿景。”广济医院普外科主任代坤表示,“通过定期坐诊、联合手术、查房,上海专家把技术留在淮南,缩短患者就医路径的同时,加快临床重点学科高品质扩容,对推动国家区域医疗中心建设意义重大。”


让淮南患者安心在“家”就医!淮南东方医院集团通过专家驻点、技术共享、学科共建等深度合作模式,让上海瑞金医院国际领先的诊疗技术和管理经验“无缝嫁接”至淮南,将沪上名医“请进来”,推动优质资源“留下来”。沪淮共建“转化中心”,上海瑞金医院专家的到来,为淮南百姓带来了高水平的诊疗服务,也为淮南地区医疗高质量发展注入新动能,未来,将有更多的上海专家常驻淮南东方医院集团,让淮南百姓真正实现“大病不出市,名医在身边”。

24小时服务电话:0554-6895999纪委:0554-6895236投诉办:0554-6895132
医院地址:安徽省淮南市洞山老龙眼
Copyright © 2025淮南东方医院集团
微信公众号
手机版


微信公众号

手机版
